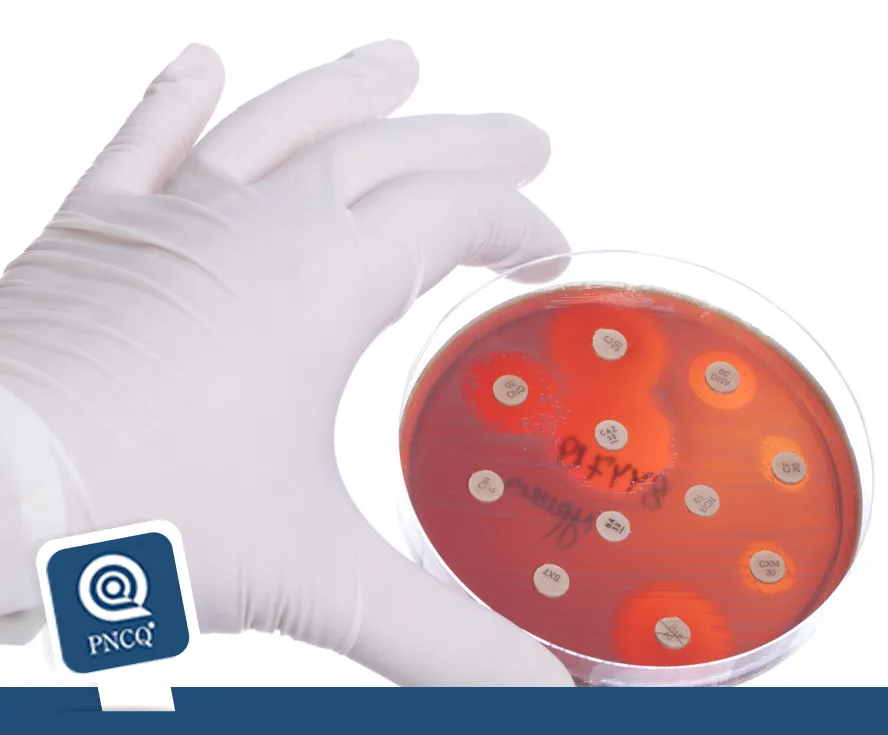
I Encontro Internacional BrCAST e EUCAST

Notícias
Últimos Posts
Notificação de casos pelo vírus Zika passa a ser obrigatória no Brasil
A partir desta quinta-feira (18/02), a notificação dos casos suspeitos de Zika será obrigatória para todos os estados do país. A medida foi publicada no Diário Oficial da União (DOU) por meio da portaria 204, de 17 de fevereiro de 20...
» Leia MaisJornal eletrônico do IFCC
A edição deste mês do Jornal da Federação Internacional de Química Clínica e Medicina laboratorial – IFCC, dedica-se à harmonização de resultados de testes de laboratório. Dois excelentes cientistas de renome – Ms. Jillian Ta...
» Leia MaisCurso de Atualização no combate vetorial ao Aedes aegypti
O número de casos de crianças com microcefalia aumentou significativamente no Brasil numa associação com a infecção com o Zika vírus, tornando-se uma emergência de Saúde pública. Diante de tal quadro, uma série de ações estão ...
» Leia MaisAutoteste de HIV/AIDS: riscos e benefícios
Com a aprovação da RDC 52:2015 da Agência Nacional de Vigilância Sanitária (Anvisa), que permite a venda de autotestes de HIV em farmácias e drogarias, o Conselho Regional de Farmácia do Rio de Janeiro (CRF-RJ) organizou um simpósio...
» Leia MaisFaça o PNCQ Gestor e ganhe descontos na Acreditação
Essa é a melhor oportunidade para fazer a Acreditação. O PNCQ tem um pacote de vantagens imperdíveis para os laboratórios que fizerem o curso PNCQ Gestor neste ano. Confira: Desconto de 50% na taxa de inscrição da Acredita�...
» Leia MaisAssinatura digital de laudos: prazo prorrogado por mais 180 dias.
A ANVISA publicou ontem no Diário Oficial (D.O.U.) a RDC 58, que prorroga por mais 180 dias o prazo estabelecido na RDC 30:2015 para a assinatura digital de laudos. Confira a RDC 58:2016...
» Leia MaisSaiu na RBAC: a comparação das equações MDRD e CKD-EPI
O artigo ‘Comparação das equações MDRD e CKD-EPI na estimativa da taxa de filtração glomerular em pacientes diabéticos e hipertensos não diagnosticados com doença renal crônica atendidos em ambulatório de um hospital universit�...
» Leia MaisI Encontro Internacional BrCAST e EUCAST
O microbiologista espanhol Prof. Rafael Cantón, coordenador geral do European Centre for Disease Prevention and Control (EUCAST) estará em São Paulo, em março, participando do I Encontro entre o Centro Europeu e o Comitê Brasileiro de ...
» Leia MaisExames para detecção de dengue e chikungunya, entre outros procedimentos, passam a ter cobertura obrigatória
Desde o último dia 2, beneficiários de planos de saúde individuais e coletivos passaram a ter cobertura a mais 21 procedimentos. A nova lista inclui o teste rápido de sangue para diagnóstico de dengue e chikungunya, para que os pacient...
» Leia MaisPalestra gratuita sobre Teste de Drogas em Cabelo, 16/01, no PNCQ
Os órgãos reguladores publicam constantemente novas normas e uma das mais recentes é sobre Testes Toxicológicos em Cabelo. O PNCQ como Provedor de Ensaio de Proficiência convidou a Dra Mayara Giatti, Farmacêutica Bioquímica do Maxila...
» Leia MaisBusca
Últimos Posts
Categorias

Inscreva-se para receber Informativos
Nosso objetivo é facilitar a obtenção de informações a respeito do funcionamento do PNCQ e sobre Controle de Qualidade e Gestão da Qualidade no labotatório, assine e fique informado(a).